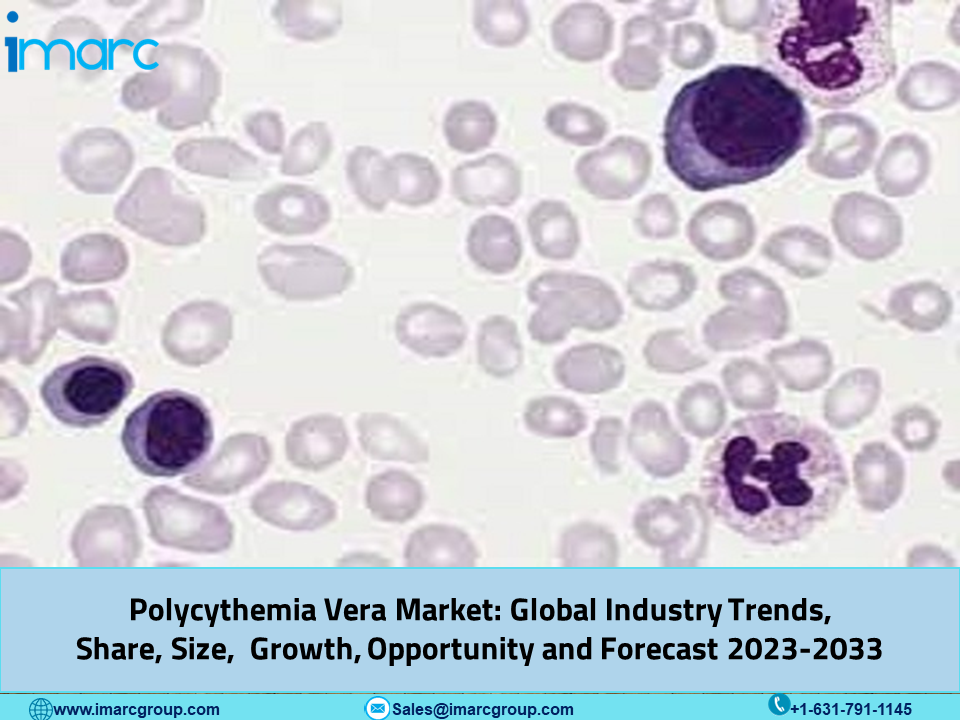

Market Overview:
Report AttributeKey StatisticsBase Year2022Forecast Years2023-2033Historical Years2017-2022Market Size in 2022US$ 1,500 MillionMarket Forecast in 2033US$ 6,338.8 MillionMarket Growth Rate (2023-2033)14%
The polycythemia vera market reached a value of US$ 1,500 Million in 2022 and expects to reach US$ 6,338.8 Million by 2033, exhibiting a growth rate (CAGR) of 14% during 2023-2033.
The polycythemia vera market offers a comprehensive analysis of the market in the United States, EU5 (including Germany, Spain, Italy, France, and the United Kingdom), and Japan. It covers aspects such as treatment methods, drugs available in the market, drugs in development, the market share of various therapies, and the market's performance in the seven major regions. Additionally, the report evaluates the performance of leading companies and their pharmaceutical products. Current and projected patient numbers across these key markets are also detailed in the report. This study is essential for manufacturers, investors, business planners, researchers, consultants, and anyone interested or involved in the polycythemia vera market.
Request for a Sample of this Report: https://www.imarcgroup.com/polycythemia-vera-market/requestsample
Polycythemia vera (PV) is a rare blood disorder characterized by the overproduction of red blood cells. In recent years, the polycythemia vera market has witnessed significant growth, driven by several key factors. Firstly, the increasing prevalence of polycythemia vera has been a major market driver. As the population ages, the incidence of polycythemia vera has been on the rise. This has led to a growing patient pool in need of effective treatments, fueling demand for polycythemia vera therapies. Additionally, advancements in medical research have played a pivotal role in driving the polycythemia vera market. Researchers have made significant strides in understanding the underlying mechanisms of polycythemia vera and have developed innovative therapies to manage the condition.
These breakthroughs have not only improved the quality of life for polycythemia vera patients but have also created lucrative opportunities for pharmaceutical companies operating in this space. Moreover, the healthcare landscape's evolving dynamics have contributed to market growth. The increasing emphasis on personalized medicine and targeted therapies has paved the way for the development of more tailored treatments for polycythemia vera. This has led to a surge in investment in R&D activities, further boosting the polycythemia vera market. Additionally, regulatory support has been a key driver in the polycythemia vera market.
Countries Covered:
• United States
• Germany
• France
• United Kingdom
• Italy
• Spain
• Japan
Analysis Covered Across Each Country:
• Historical, current, and future epidemiology scenario
• Historical, current, and future performance of the polycythemia vera market
• Historical, current, and future performance of various therapeutic categories in the market
• Sales of various drugs across the polycythemia vera market
• Reimbursement scenario in the market
• In-market and pipeline drugs
This report also provides a detailed analysis of the current polycythemia vera marketed drugs and late-stage pipeline drugs.
In-Market Drugs:
• Drug Overview
• Mechanism of Action
• Regulatory Status
• Clinical Trial Results
• Drug Uptake and Market Performance
Late-Stage Pipeline Drugs:
• Drug overview
• Mechanism of action
• Regulatory status
• Clinical trial results
• Drug uptake and market performance
Competitive Landscape:
The competitive landscape of the polycythemia vera market has been studied in the report with the detailed profiles of the key players operating in the market.
Ask Analyst for Customization and Explore Full Report With TOC & List of Figures: https://www.imarcgroup.com/request?type=report&id=7506&flag=C
If you need specific information that is not currently within the scope of the report, we will provide it to you as a part of the customization.
About Us
IMARC Group is a leading market research company that offers management strategy and market research worldwide. We partner with clients in all sectors and regions to identify their highest-value opportunities, address their most critical challenges, and transform their businesses.
IMARC’s information products include major market, scientific, economic and technological developments for business leaders in pharmaceutical, industrial, and high technology organizations. Market forecasts and industry analysis for biotechnology, advanced materials, pharmaceuticals, food and beverage, travel and tourism, nanotechnology and novel processing methods are at the top of the company’s expertise.
Media Contact:
Company Name: IMARC Group
Contact Person: Elena Anderson
Email: [email protected]
Phone: +1-631-791-1145
Address: 134 N 4th St
City: Brooklyn
State: NY
Country: United States
Website: https://www.imarcgroup.com/

Comments